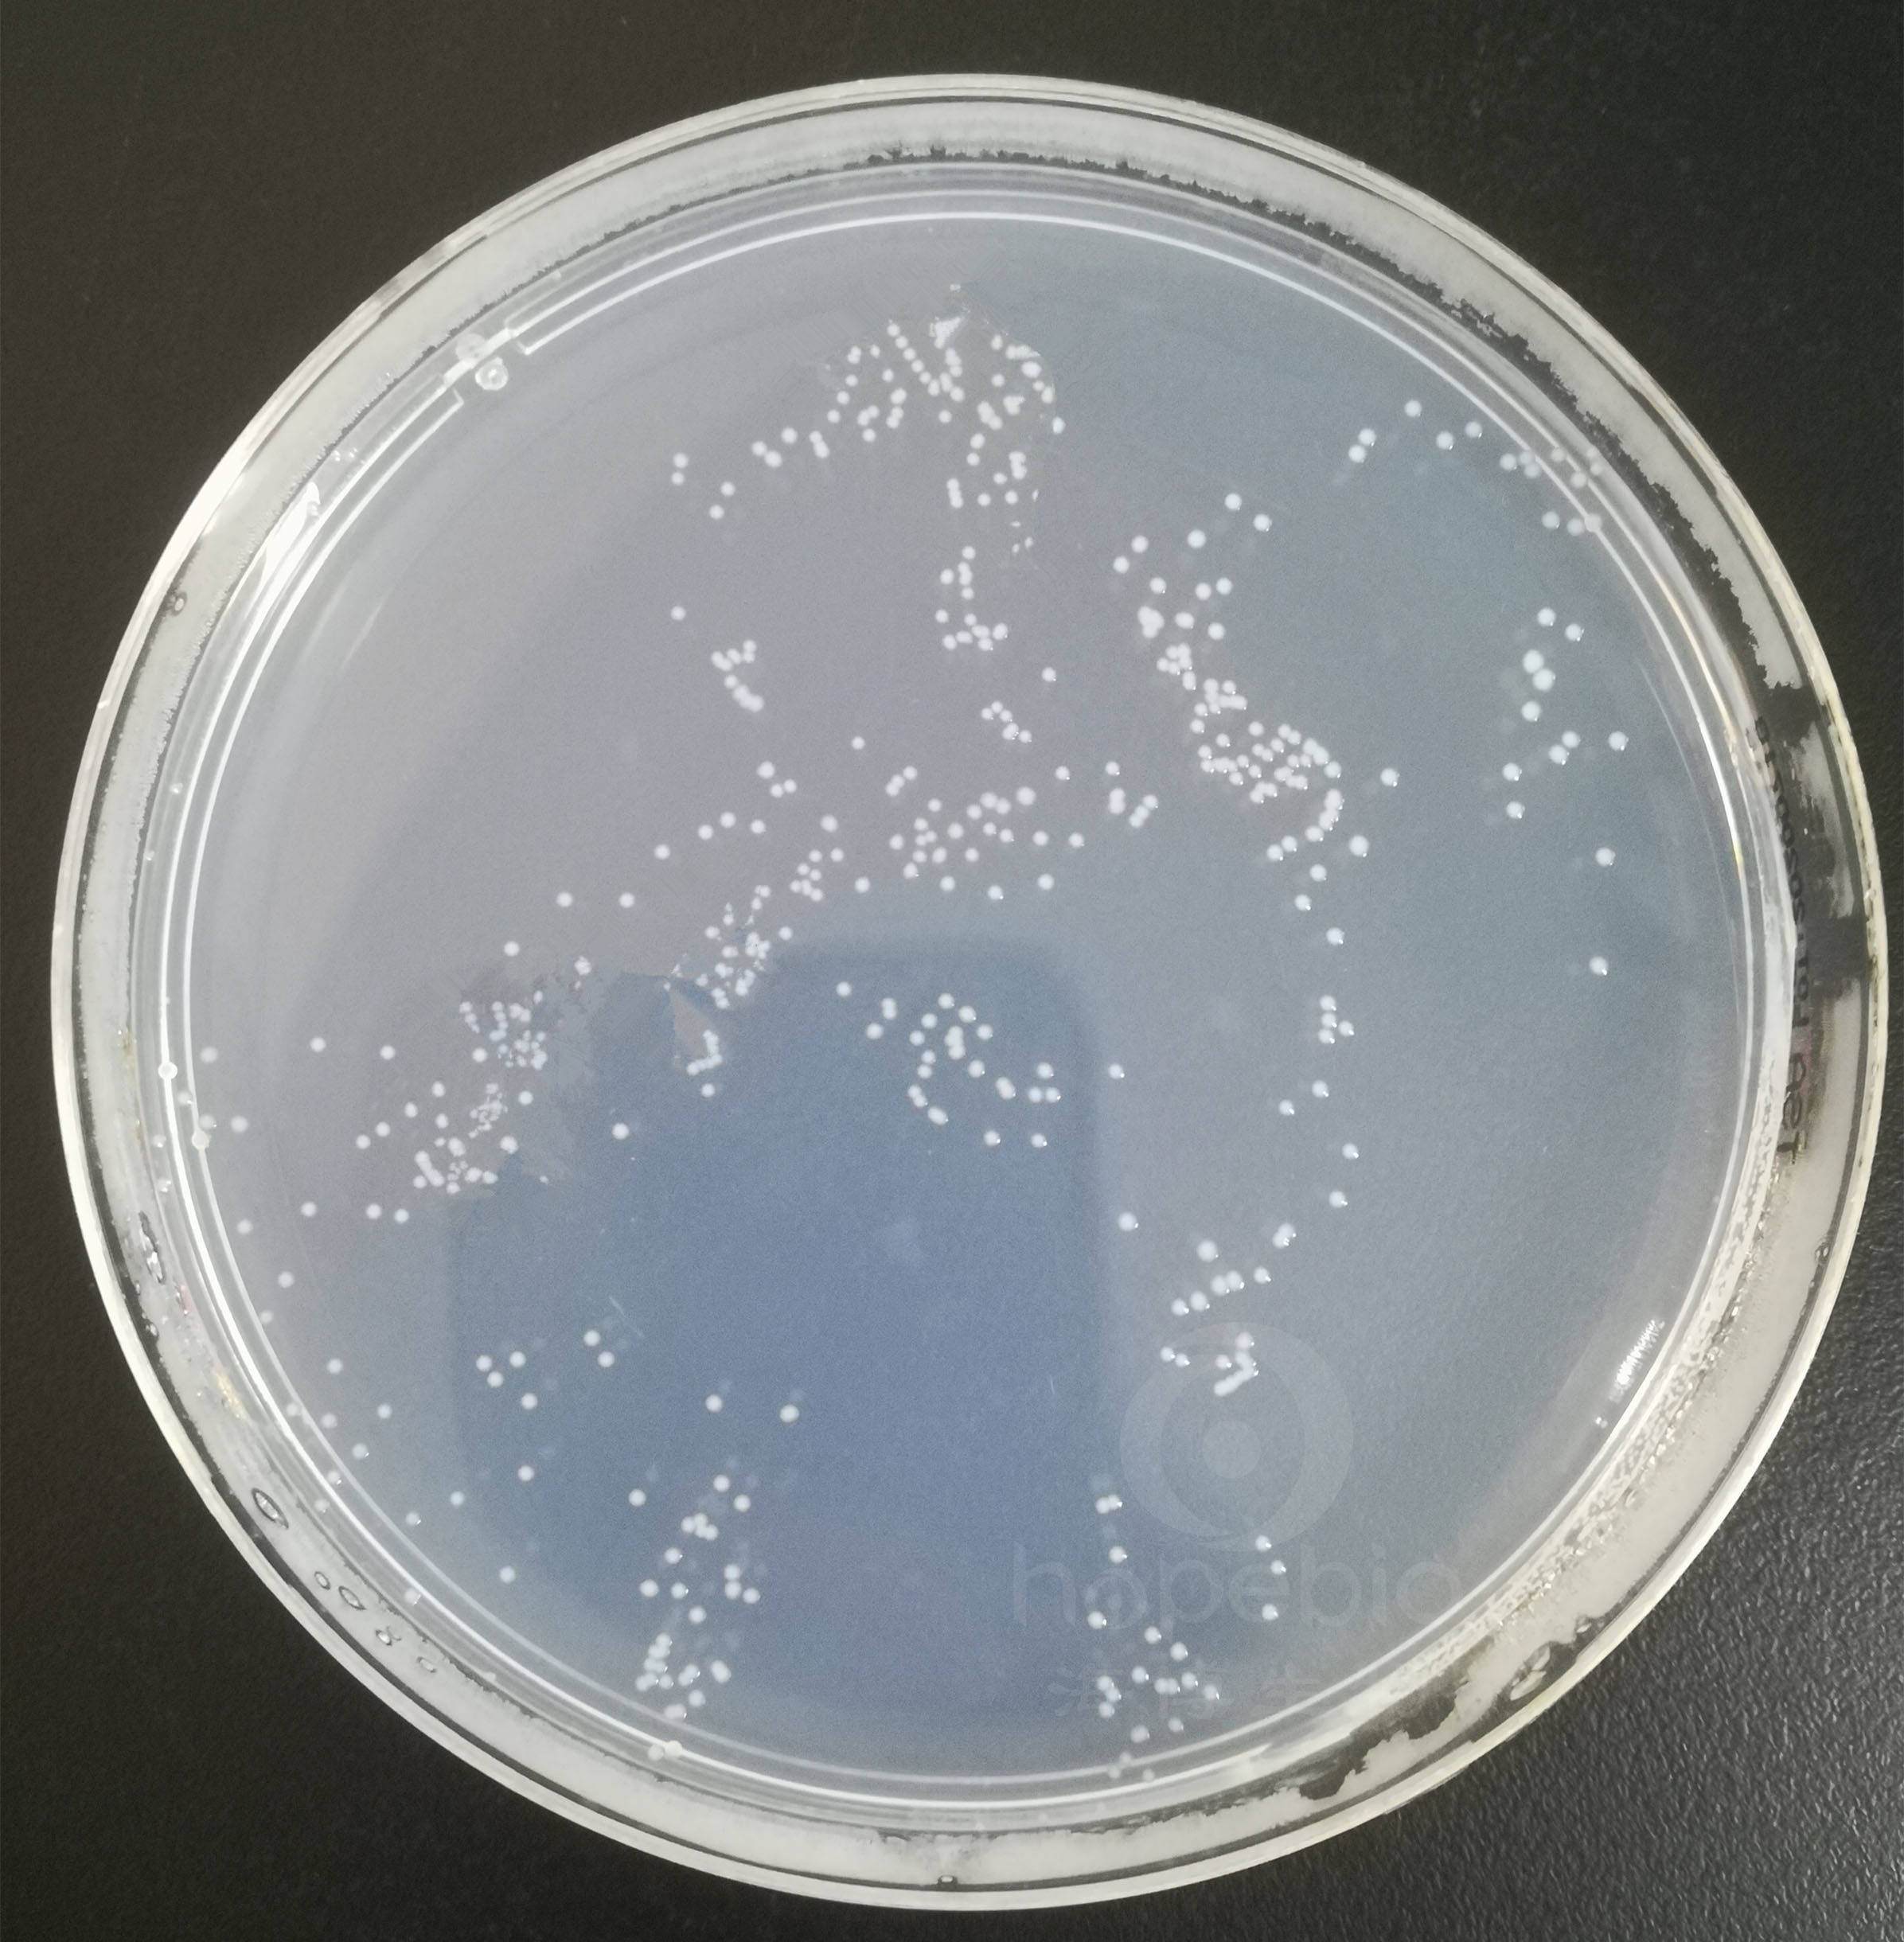

海博微信公众号
海博微信公众号
 海博天猫旗舰店
海博天猫旗舰店


 海博微信公众号
海博微信公众号
 海博天猫旗舰店
海博天猫旗舰店




一、参考标准:
《GB4789.29-2020食品安全国家标准 食品微生物学检验 唐菖蒲伯克霍尔德氏菌(椰毒假单胞菌酵米面亚种)检验》。
二、菌种特征:
1、生物学特性:
革兰氏阴性杆菌,长2.5-3μm,宽0.5-1.0μm,呈杆状、球杆状或稍弯曲,两端钝圆,无芽胞,有鞭毛。本菌为兼性厌氧,但易在表面生长。最适生长温度为37℃,最适产毒温度为26℃。pH 5-7范围内生长较好。
2、流行病学特点:
椰毒假单胞菌酵米面亚种(Psedomonas cocovenenans subsp.farino fermentans)是我国发现的一种食物中毒菌,为唐菖蒲伯克霍尔德氏菌(Burkholderia gladioli)的一个病原型。它存在于发酵的玉米、糯玉米、黄米、高梁米、变质银耳以及周围环境中,它是酵米面及变质银耳中毒的病原菌。该菌产生的毒素米酵菌酸是其致病原因。该食物中毒的主要症状,开始患者感到上腹部不适,少数出现腹泻、恶心、呕吐,呕吐物多为咖啡色,严重者出现黄疸、昏迷、四肢抽搐、少尿、血尿、便血和尿潴留,呈现休克而死亡。目前尚无特效的治疗办法。
三、培养基原理分析及结果:
1、改良马铃薯葡萄糖琼脂(mPDA)(点击此查看培养基详情)
原理:马铃薯为微生物的生长提供各类氮源、碳源、维生素,葡萄糖提供能源,琼脂是培养基的凝固剂,氯霉素可抑制细菌的生长,龙胆紫抑制真菌的生长。
结果:培养24 h后,菌落1 mm-2 mm,紫色,光滑、湿润、边缘整齐;培养48h后,部分菌落中心可有呈草帽状凸起。如图一。
图一 唐菖蒲伯克霍尔德氏菌ATCC10248培养48h
原理:PCFA培养基基础中的氯化铵为微生物的生长提供氮源;磷酸二氢钾和磷酸氢二钠是缓冲剂;氯化钠可维持细胞渗透压;氯化钙、硫酸镁和硫酸亚铁为微生物生长提供微量元素;葡萄糖和胱氨酸用于唐菖蒲伯克霍尔德氏菌代谢酶的合成;卫矛醇可为微生物生长提供碳源;琼脂是培养基凝固剂。配套添加剂可抑制大肠埃希氏菌、铜绿假单胞菌、肺炎克雷伯氏菌等革兰氏阴性杆菌生长,同时也可抑制大部分革兰氏阳性球菌的生长。
结果:培养24 h后,菌落0.5 mm-1 mm,灰白色,光滑、湿润、边缘整齐。如图二。
图二 唐菖蒲伯克霍尔德氏菌ATCC10248培养48h
3、卵黄琼脂
原理:蛋白胨和牛肉粉提供碳氮源、维生素和生长因子;葡萄糖提供能源;氯化钠维持均衡的渗透压;琼脂是培养基的凝固剂;具有卵磷脂酶的细菌可分解卵磷脂生成不溶性甘油酯,从而形成乳白色的混浊带。
结果:培养24 h后,菌落2 mm-3 mm,表面光滑、湿润;培养48 h后,菌落周围形成乳白色混浊环,斜射光下可见菌落及周围培养基表面呈虹彩现象。如图三。

图三 唐菖蒲伯克霍尔德氏菌ATCC10248培养48h
四、生化鉴定原理及结果分析:
1、革兰氏染色
试验所用试剂:革兰氏染色液试剂盒。
原理:革兰氏阳性菌由于其细胞壁较厚、肽聚糖网层次较多且交联致密,故遇乙醇或丙酮脱色处理时,因失水反而使网孔缩小,再加上它不含类脂,故乙醇处理不会出现缝隙,因此,能把结晶紫与碘复合物牢牢留在壁内,使其仍呈紫色;而革兰氏阴性菌因其细胞壁薄、外膜层类脂含量高、肽聚糖层薄且交联度差,在遇脱色剂后,以类脂为主的外膜迅速溶解,薄而松散的肽聚糖网不能阻挡结晶紫与碘复合物的溶出,因此通过乙醇脱色后仍呈无色,再经沙黄等红色染料复染,就使革兰氏阴性菌呈红色。
结果:革兰氏阴性,菌体呈短杆状,单个或成对排列。如图四所示。

图四
2、氧化酶试验
试验所用试剂:氧化酶试纸。
原理:氧化酶即细胞色素氧化酶,为细胞色素呼吸酶系统的终末呼吸酶,氧化酶先使细胞色素C氧化,然后此氧化型细胞色素C再使对苯二胺氧化,产生颜色反应。在 30s内变为蓝色或蓝紫色为强阳性,2min内不变色为阴性。
结果:不变色,为阴性。如图五

图五 左:唐菖蒲伯克霍尔德氏菌ATCC10248 右:铜绿假单胞菌ATCC9027
3、尿素酶试验
试验所用试剂:尿素酶生化管。
原理:有些细菌能产生尿素酶,将尿素分解、产生氨,使培养基变碱呈粉红色。
结果:培养基变为粉红色,为阳性。如图六。

左:唐菖蒲伯克霍尔德氏菌ATCC10248 右:大肠埃希氏菌ATCC25922
图六
4、柠檬酸盐利用试验
试验所用培养基:西蒙氏枸橼酸盐培养基。
原理:西蒙氏枸橼酸盐培养基中氯化钠维持均衡的渗透压,镁离子是各种代谢中的辅因子,磷酸二氢铵提供氮源,磷酸氢二钾是缓冲剂,柠檬酸钠作为碳源,琼脂是培养基的凝固剂,溴麝香草酚兰为pH 指示剂。当细菌可以利用铵盐作为唯一的氮源,同时利用柠檬酸盐作为唯一的碳源时,可在柠檬酸盐培养基上生长,分解柠檬酸钠,生成碳酸钠,使培养基产碱变蓝色。
结果:培养基变蓝,为阳性。如图七。

左:大肠埃希氏菌ATCC25922 右:唐菖蒲伯克霍尔德氏菌ATCC10248
图七
5、石蕊牛奶试验
试验所用培养基:石蕊牛奶培养基。
原理:牛奶中含有乳糖以及三种主要的蛋白质,即酪蛋白、乳清蛋白和乳球蛋白。在石蕊牛奶培养基中,微生物可能表现出一种或几种代谢特性,每一种特性专属于特定 菌种,可以辅助细菌的鉴定。这些代谢特性包括乳糖发酵、石蕊还原、凝乳产生、胨化(蛋白消化)和产气。石蕊是良好的酸碱指示剂,自身的氧化还原特性及对细菌的低毒性(相对于溴甲酚紫)使得石蕊成分十分有用的牛奶培养基指示剂。
结果:顶部淡紫色,底部乳白色。如图八。

左:空白对照 右:唐菖蒲伯克霍尔德氏菌ATCC10248
图八
6、靛基质试验
试验所用培养基、试剂:蛋白胨水(色氨酸肉汤)、Kovacs靛基质试剂。
原理:蛋白胨为微生物的生长提供碳氮源、维生素和生长因子;氯化钠维持均衡的渗透压;含有色氨酸酶的细菌,能分解蛋白胨中的色氨酸,形成靛基质(吲哚),靛基质无色,当加入对氨基苯甲酸试剂后,形成可见的红紫色醌式化合物,即玫瑰靛基质。
结果:滴加Kovacs靛基质试剂后产生黄色环,为阴性。如图九

左:唐菖蒲伯克霍尔德氏菌ATCC10248 右:大肠埃希氏菌ATCC25922
图九
注:唐菖蒲伯克霍尔德氏菌其它生化特征见下表。
|
生化试验 |
特征 |
|
O/F试验(氧化型) |
+ |
|
氧化 |
|
|
葡萄糖 |
+ |
|
果糖 |
+ |
|
木糖 |
+ |
|
半乳糖 |
+ |
|
蔗糖 |
- |
|
阿拉伯糖 |
+ |
|
甘露醇 |
+ |
|
侧金盏花醇 |
+ |
|
肌醇 |
+ |
|
卫茅醇 |
+ |
|
动力 |
+ |
|
卵磷脂酶 |
+ |
|
氧化酶 |
- |
|
尿素 |
+ |
|
明胶液化 |
+ |
|
硝酸盐还原 |
+ |
|
柠檬酸盐利用 |
+ |
|
精氨酸 |
+ |
|
石蕊牛乳 |
+ |
|
靛基质 |
- |
|
V-P |
- |
|
MR |
- |
|
苯丙氨酸脱氨酶 |
- |
|
H2S产生 |
- |
|
注:+表示阳性;-表示阴性。 |
|
注:本文属海博生物原创,未经允许不得转载。
上一篇:产气荚膜梭菌检验解析及注意事项
下一篇:食品中大肠菌群的计数方法



